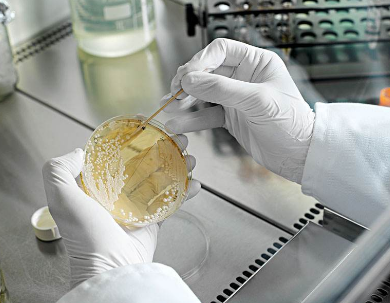

二氧化碳培养箱的设计是为了模拟细胞的自然环境,并确保条件是恒定的。虽然培 养箱有不同的类型,但大多数的设计是为了将CO2、相对湿度、温度和 PH值控制在恒定的水 平。新的高速二氧化碳传感器现在已经出现,它可以让设计者以前所未有的近乎实时的来响应 和管理气体浓度。 什么是培养箱? 微生物培养箱本质上是一种温度可控的烘箱,在严格的生物范围内工作,主要用于培养 和储存微生物培养物。这些孵化器可以在世界各地的实验室中找到,是必不可少的设备。医学 和生物实验室都使用培养箱来为成功培养提供正确的受控环境。 为什么需要测量二氧化碳? 培养箱中的培养物需要非常特殊的环境条件。通常情况下,恒温箱允许用户监控和调整不同的条件,如温度、相对湿度和二氧化碳水平,由此控制培养基的 PH 值,确保并维持最佳的生长或储存条件。 细胞生长是通过控制 PH 值来控制的,PH 值通常在 7.0 到 7.7 之间。介质中的化学反应 可以改变 PH 值。为了对抗这些反应,控制CO2水平有助于维持一个稳定的生长介质的 PH 值 平衡。 如果大气中没有足够的CO2, 那么细胞媒介会释放二氧化碳,因此物质会变得偏碱性。过 高的二氧化碳浓度会导致更多的二氧化碳气体被混合物吸收,从而导致偏酸性。提供一个可以 控制二氧化碳的环境有助于维持在生长介质所需的二氧化碳的含量, 以及稳定的 PH 值。 二氧化碳传感器的要求是什么? 细胞培养箱中使用的 CO2传感器应具有较好的响应性、准确性和稳定性。培养箱内总是 会发生一些不确定的变化,由此可能会对培养产生负面影响,因此了解 CO2浓度何时发生变 化以及变化的程度并能够做出相应的反应是至关重要的。由于高湿度的环境,还需要采取方法 以减轻高湿度水平的影响,特别是在消毒过程中,传感器上的冷凝会导致传感器报告不准确的 结果。 拥有一个快速的二氧化碳传感器检测二氧化碳气体水平的变化,培养箱的设置可以近乎 实时地进行调整,进而减少了培养箱环境偏离标准的机会。 NDIR 二氧化碳传感器 工采网是GSS的代理商,代理的二氧化碳传感器采用固态超低功率 LED 光源。这种类型的光源有许多优点,特别 是在低功耗应用中。二氧化碳气体被中红外 4. 25 微米的光强有力的吸收。GSS 制造自己的 LED,其专门设计为发出 4. 25um 的窄波段光。 GSS 设计了一个高速、高响应率的CO2传感器系列,其专门针对需要接近实时测量 CO2 浓度的应用。 SprintIR-6S 和 ExplorIR-W 的介绍 SprintIR-6S 和 ExplorIR-W 系列传感器是一系列高精度的CO2传感器,旨在 满足需要快速测量 CO2水平的客户的需求。SprintIR-6S 和 ExplorIR-W 传感器的读数分别是 是每秒 20 次和 2 次。这两款传感器的光腔专门配置了流通适配器,使气体能够高速流过传感 器,进而用户可以得到高速率的测量结果。
|

提升卡
提升卡 置顶卡
置顶卡 沉默卡
沉默卡 喧嚣卡
喧嚣卡 变色卡
变色卡 千斤顶
千斤顶 显身卡
显身卡














